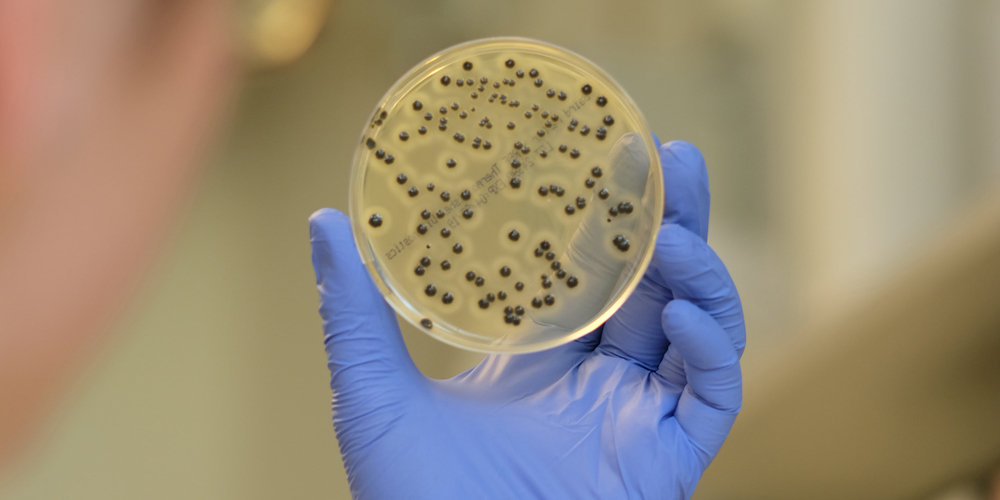
Das 50-köpfige Team des Laboratoriums der Urkantone hat seit 2019 insgesamt 215 Trinkwasserproben auf Pflanzenschutzmittelrückstände untersucht.

In den vergangenen Jahrzehnten hat sich die Wasserqualität der Seen und Flüsse in der Schweiz in Bezug auf Nährstoffe stark verbessert. Laut dem Bundesamt für Lebensmittelsicherheit und Veterinärwesen (BLV) liegt der Grund dafür im Bau und der Verbesserung von Abwasserreinigungsanlagen. Trotzdem sind die Gewässer, vor allem kleinere, insbesondere aufgrund von Mikroverunreinigungen nicht überall in der Lage, ihre für Mensch und Ökosysteme wichtigen Funktionen zu erfüllen. Und: In Einzugsgebieten mit intensiver Landwirtschaft oder grossem Siedlungsflächenanteil sind einzelne Seen zu stark mit Phosphor belastet. Dort sind oft auch Rückstände von Düngemitteln, Pflanzenschutzmitteln und weiteren künstlichen organischen Substanzen zu finden.
Beruhigende Ergebnisse
Seit 2019 untersucht das Laboratorium der Urkantone unser Trinkwasser daher regelmässig auf Pflanzenschutzmittelrückstände. Die Ergebnisse dieser Untersuchungen zeigen ein klares und positives Bild: Alle 215 untersuchten Trinkwasserproben entsprachen den gesetzlichen Vorgaben. Im ersten Jahr wurden 66, im zweiten Jahr 149 Wasserproben auf 60 verschiedene Substanzen von Pflanzenschutzmitteln inklusive Chlorothalonil und seine Metaboliten untersucht. Dem Trinkwasser in den Urkantonen kann also eine gute Qualität attestiert werden.
Untersucht wurde im letzten Jahr auch die Milch. Denn wenn Landwirte mit Pestiziden arbeiten, findet man die Chemikalien auch in der Milch der Kühe vor. Der Konsum von Pestizidrückständen kann im Menschen und beim Tier die Zellteilung stören, das Entstehen von Krebs begünstigen, das Erbgut verändern, das Immunsystem beeinträchtigen oder auch Allergien auslösen. Doch auch hier gibt es gute Nachrichten: Von den 42 untersuchten Rohmilchproben wurde nur in einer Probe ein Pestizid nachgewiesen – jedoch unterhalb des Rückstandshöchstwertes. Die Proben waren auf dem Bauern-hof, aus Milchsammeltanks und Milchautomaten sowie an Milchsammelstellen entnommen worden.
Keine Keime gefunden
Aufgrund der Schliessung von Gastronomiebetrieben im letzten Jahr sind weniger Lebensmittel- (-5 %) und weniger Chemikalienkontrollen durchgeführt worden (- 24 %). Wie das Laboratorium der Urkantone schreibt, habe es die Betriebe während dieser Zeit in Bezug auf das Take-away unterstützt. So sind im letzten Jahr 2116 Lebens-mittelinspektionen durchgeführt worden.
Krankmachende Salmonellen, Listerien oder Kolibakterien wurden in keiner Probe nachgewiesen. Bei einem Sechstel der untersuchten Betriebe sei die Dokumentation der -Selbstkontrolle ungenügend gewesen. Knapp jedes fünfte Lebensmittel habe beanstandet werden müssen, da Prozesse und Tätigkeiten «nicht konform» waren.